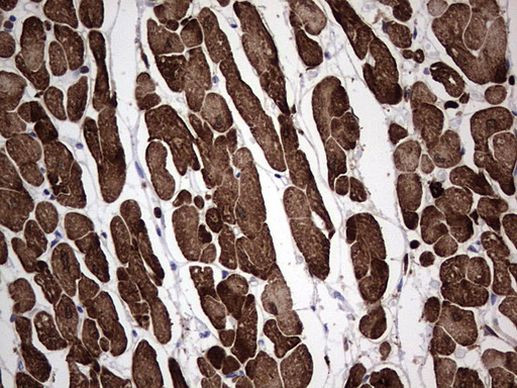
TNNC1 Antibody in Immunohistochemistry (Paraffin) (IHC (P))

Search
OriGene
TNNC1 Monoclonal Antibody (OTI1H5), TrueMAB™
{{$productOrderCtrl.translations['antibody.pdp.commerceCard.promotion.promotions']}}
{{$productOrderCtrl.translations['antibody.pdp.commerceCard.promotion.viewpromo']}}
{{$productOrderCtrl.translations['antibody.pdp.commerceCard.promotion.promocode']}}: {{promo.promoCode}} {{promo.promoTitle}} {{promo.promoDescription}}. {{$productOrderCtrl.translations['antibody.pdp.commerceCard.promotion.learnmore']}}
产品信息
TA804824
种属反应
宿主/亚型
分类
类型
克隆号
抗原
偶联物
形式
浓度
纯化类型
保存液
内含物
保存条件
运输条件
靶标信息
Troponin (Tn) is the central regulatory protein of striated muscle contraction. Tn consists of three components: Tn-I which is the inhibitor of actomyosin ATPase, Tn-T which contains the binding site for tropomyosin and Tn-C. The binding of calcium to Tn-C abolishes the inhibitory action of Tn on actin filaments, and as a result of calcium-ion uptake by troponin-C, the elements of the muscle thin filament undergo a series of allosteric changes which allow the interaction of actin with myosin, the hydrolysis of ATP, and the generation of tension.
仅用于科研。不用于诊断过程。未经明确授权不得转售。
篇参考文献 (0)
生物信息学
蛋白别名: cardiac 3; cardiac troponin C; Cardiac troponin I; CMD1FF; CMD2A; CMH7; MGC116817; RCM1; slow twitch skeletal/cardiac muscle troponin C; TN-C; Tn1; Tni; TNN I3; TNNC 1; TNNI3; troponin C type 1 (slow); Troponin C, slow skeletal and cardiac muscles; troponin C1, slow; Troponin I; Troponin I cardiac; TroponinI
基因别名: CMD1Z; CMH13; TN-C; TNC; TNNC; TNNC1
UniProt ID: (Human) P63316
Entrez Gene ID: (Human) 7134